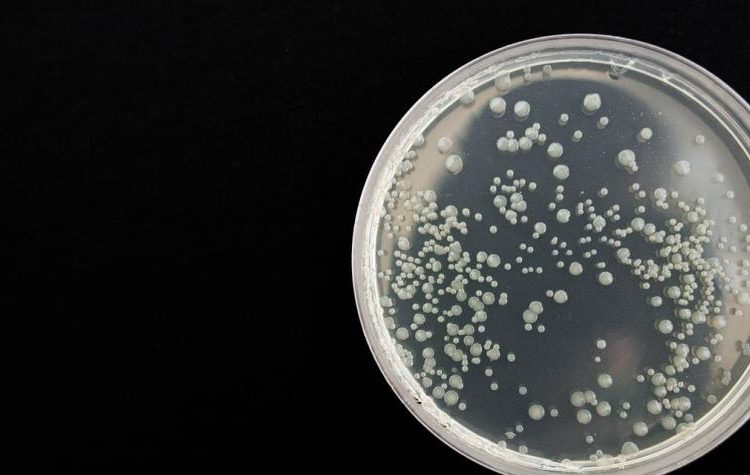
Médico boliviano se convierte en la tercera víctima del arenavirus

La mañana del miércoles, en La Paz, Bolivia, un médico que trabajaba en cuidados intensivos murió luego de que fue probamente contagiado por el arenavirus.
El galeno que respondía al nombre de Gustavo Vidales, podría ser la tercera persona que muere víctima de este virus, el cual tuvo los síntomas de fiebre hemorrágica, además de dolor abdominal, molestar en cabeza y dolores musculares.
Cabe mencionar que a principios del mes de junio esta patología fue descubierta, luego de que falleció un médico interno y un residente en Caranavi, provincia de Yungas, a 160 kilómetros de la capital.
Algunos especialistas asocian a este virus por la presencia de roedores, los cuales infectan a los humanos con el virus, hasta causarles la muerte, según el Centro de Control de Enfermedades en Atlanta.

Hasta haya a llegado este virulento partido Arena, contra coño. Jajajaja
Esto deberia ser muy preocupante en vez de pelear por otras pendejadas ….
Roedores COENA llegaron al Peru
LA RAZA HUMANA VA A SUCUMBIR VA A COLAPSAR MUY MUY PRONTO, MAS PRONTO DE LO QUE TODOS INCLUSO LA CIENCIA TIENE CALCULADO, TODO POR EL DESORDEN DESMEDIDO Y LA AMBICION INCONSCIENTE, QUE VENGA EL LLANTO Y EL CRUGIR DE DIENTES